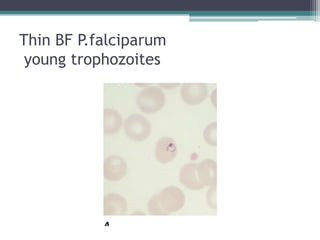
Thin BF P.falciparum
 young trophozoites

This document discusses the diagnosis of malaria through microscopic examination of blood smears. Peripheral blood smears can be used to identify the asexual forms of the malaria parasite. Thick blood smears are more sensitive for detection of low-level parasitemia but thin smears are needed for species identification. Rapid diagnostic tests are also used to detect malaria antigens but cannot identify the parasite species or quantify the level of infection. Clinical symptoms may also indicate malaria in endemic areas but laboratory confirmation is needed for accurate diagnosis.

![electrolytes, blood urea nitrogen (BUN), and creatinine
are usually normal.
severe malaria may - metabolic acidosis, hypoglycemia,
low sodium, bicarbonate, calcium, phosphate, and
albumin together with elevations in lactate, BUN,
creatinine, urate, muscle and liver enzymes, and
conjugated and unconjugated bilirubin.
Hypergammaglobulinemia is usual in immune and semi-
immune subjects. Urinalysis generally gives normal
results. In adults and children with cerebral malaria, the
mean opening pressure at lumbar puncture is ~160 mm
of cerebrospinal fluid (CSF); usually the CSF is normal
or has a slightly elevated total protein level [<1.0 g/L ]
and cell count (<20/L)](https://image.slidesharecdn.com/malaria-investigations-121017102421-phpapp01/85/MALARIA-DIAGNOSIS-36-320.jpg)
